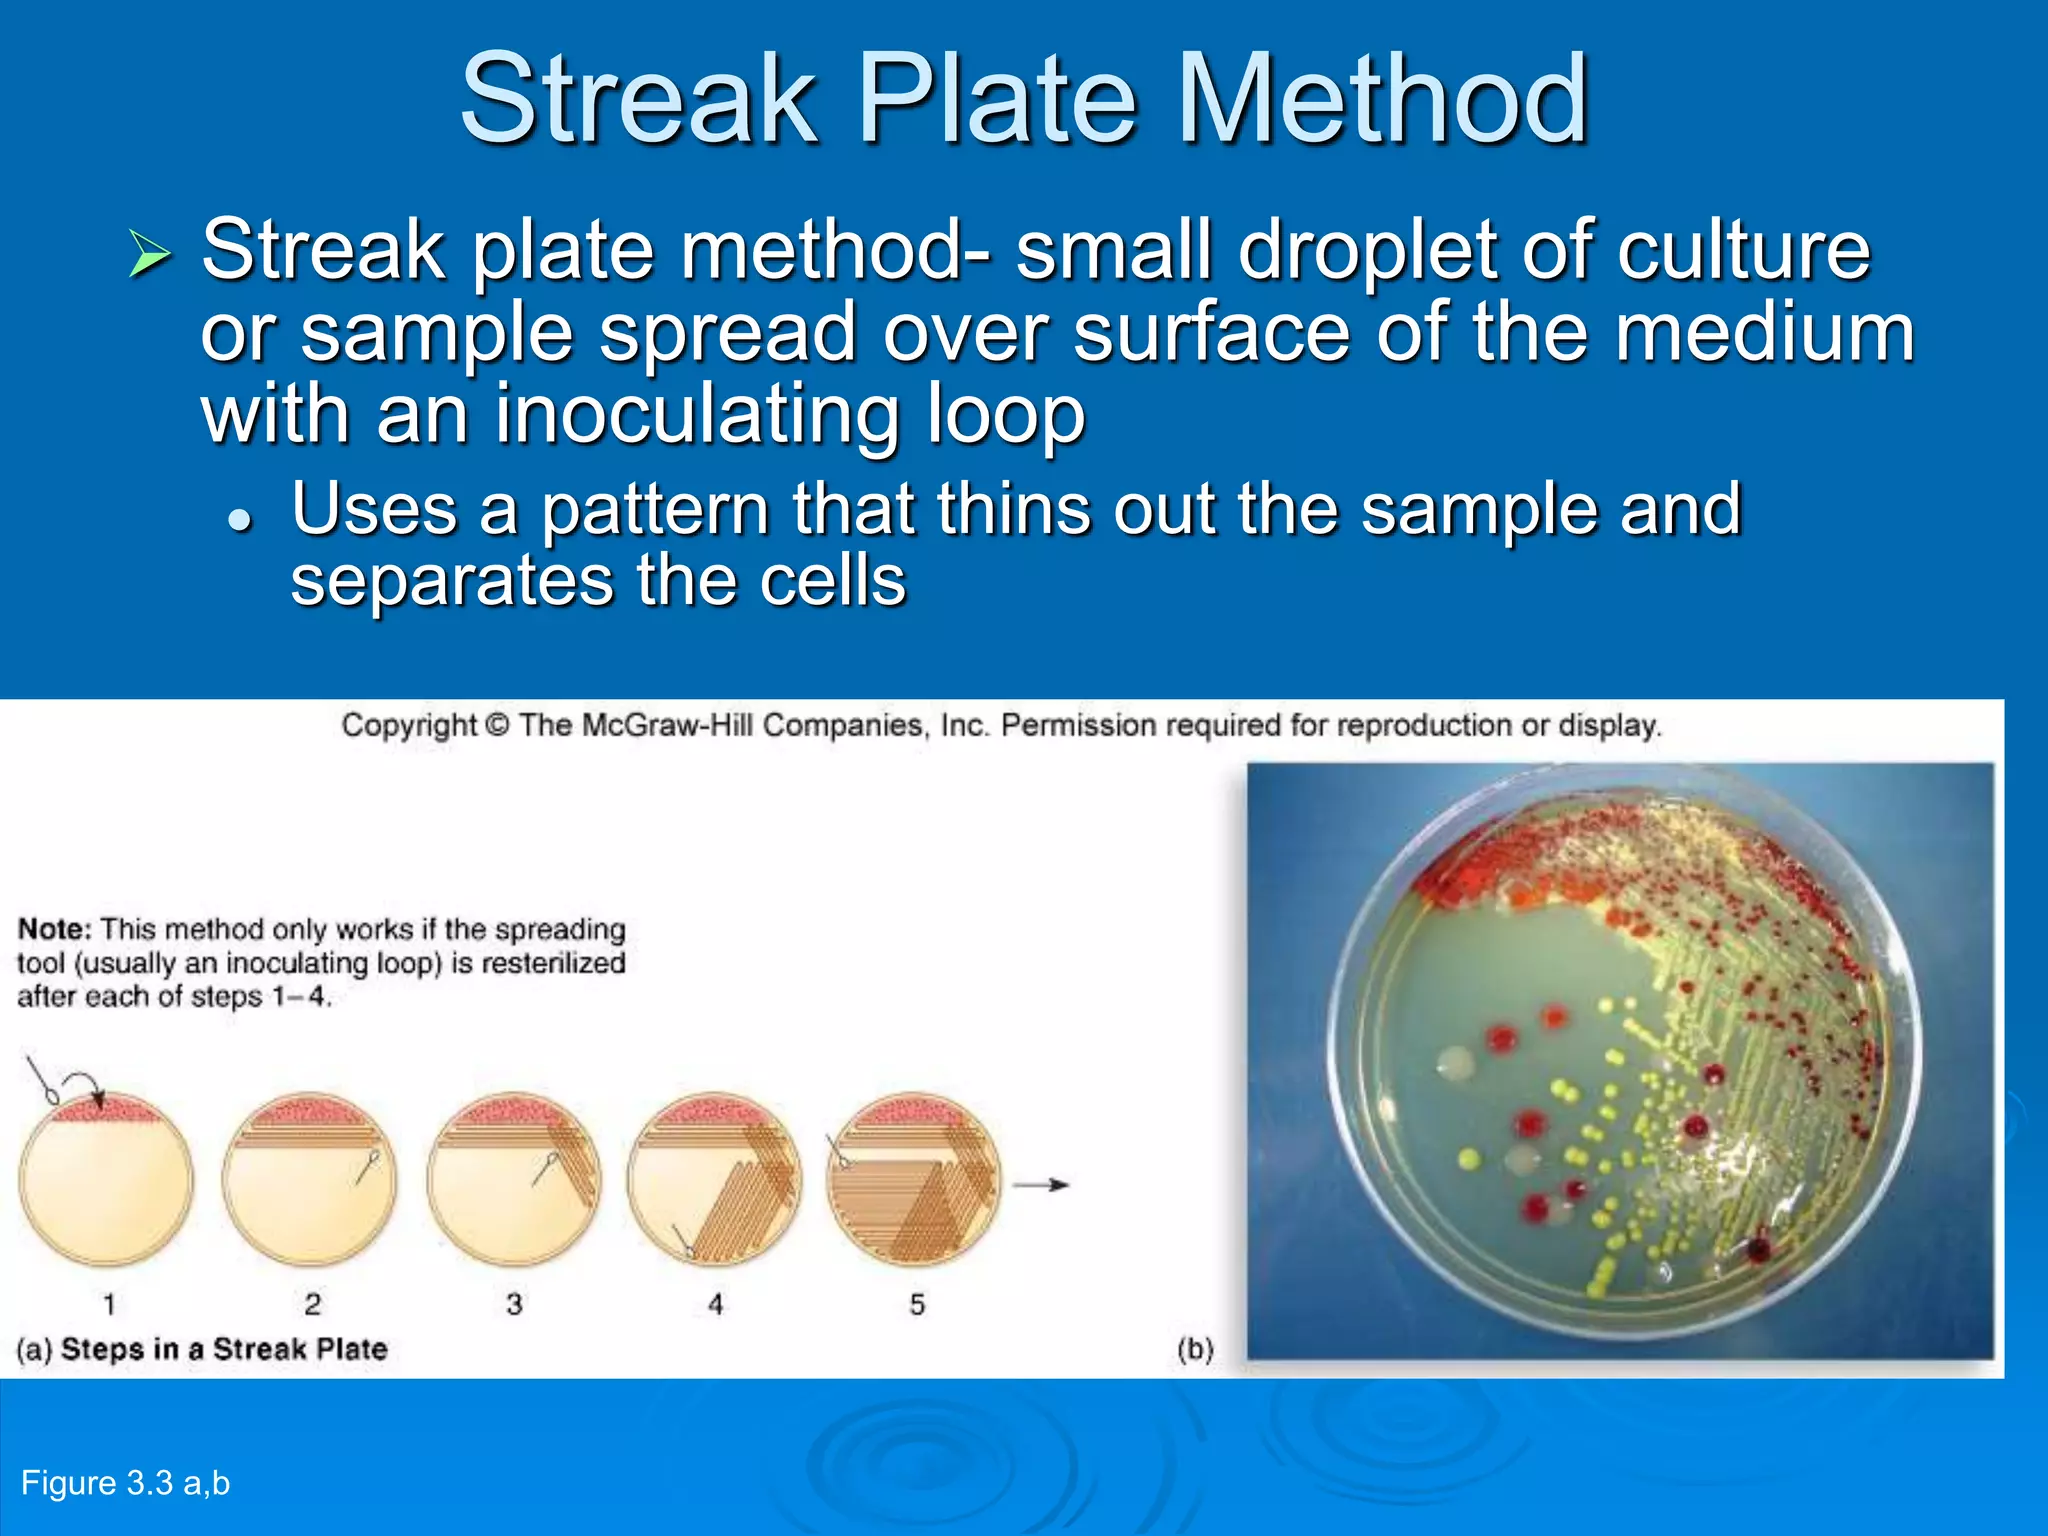
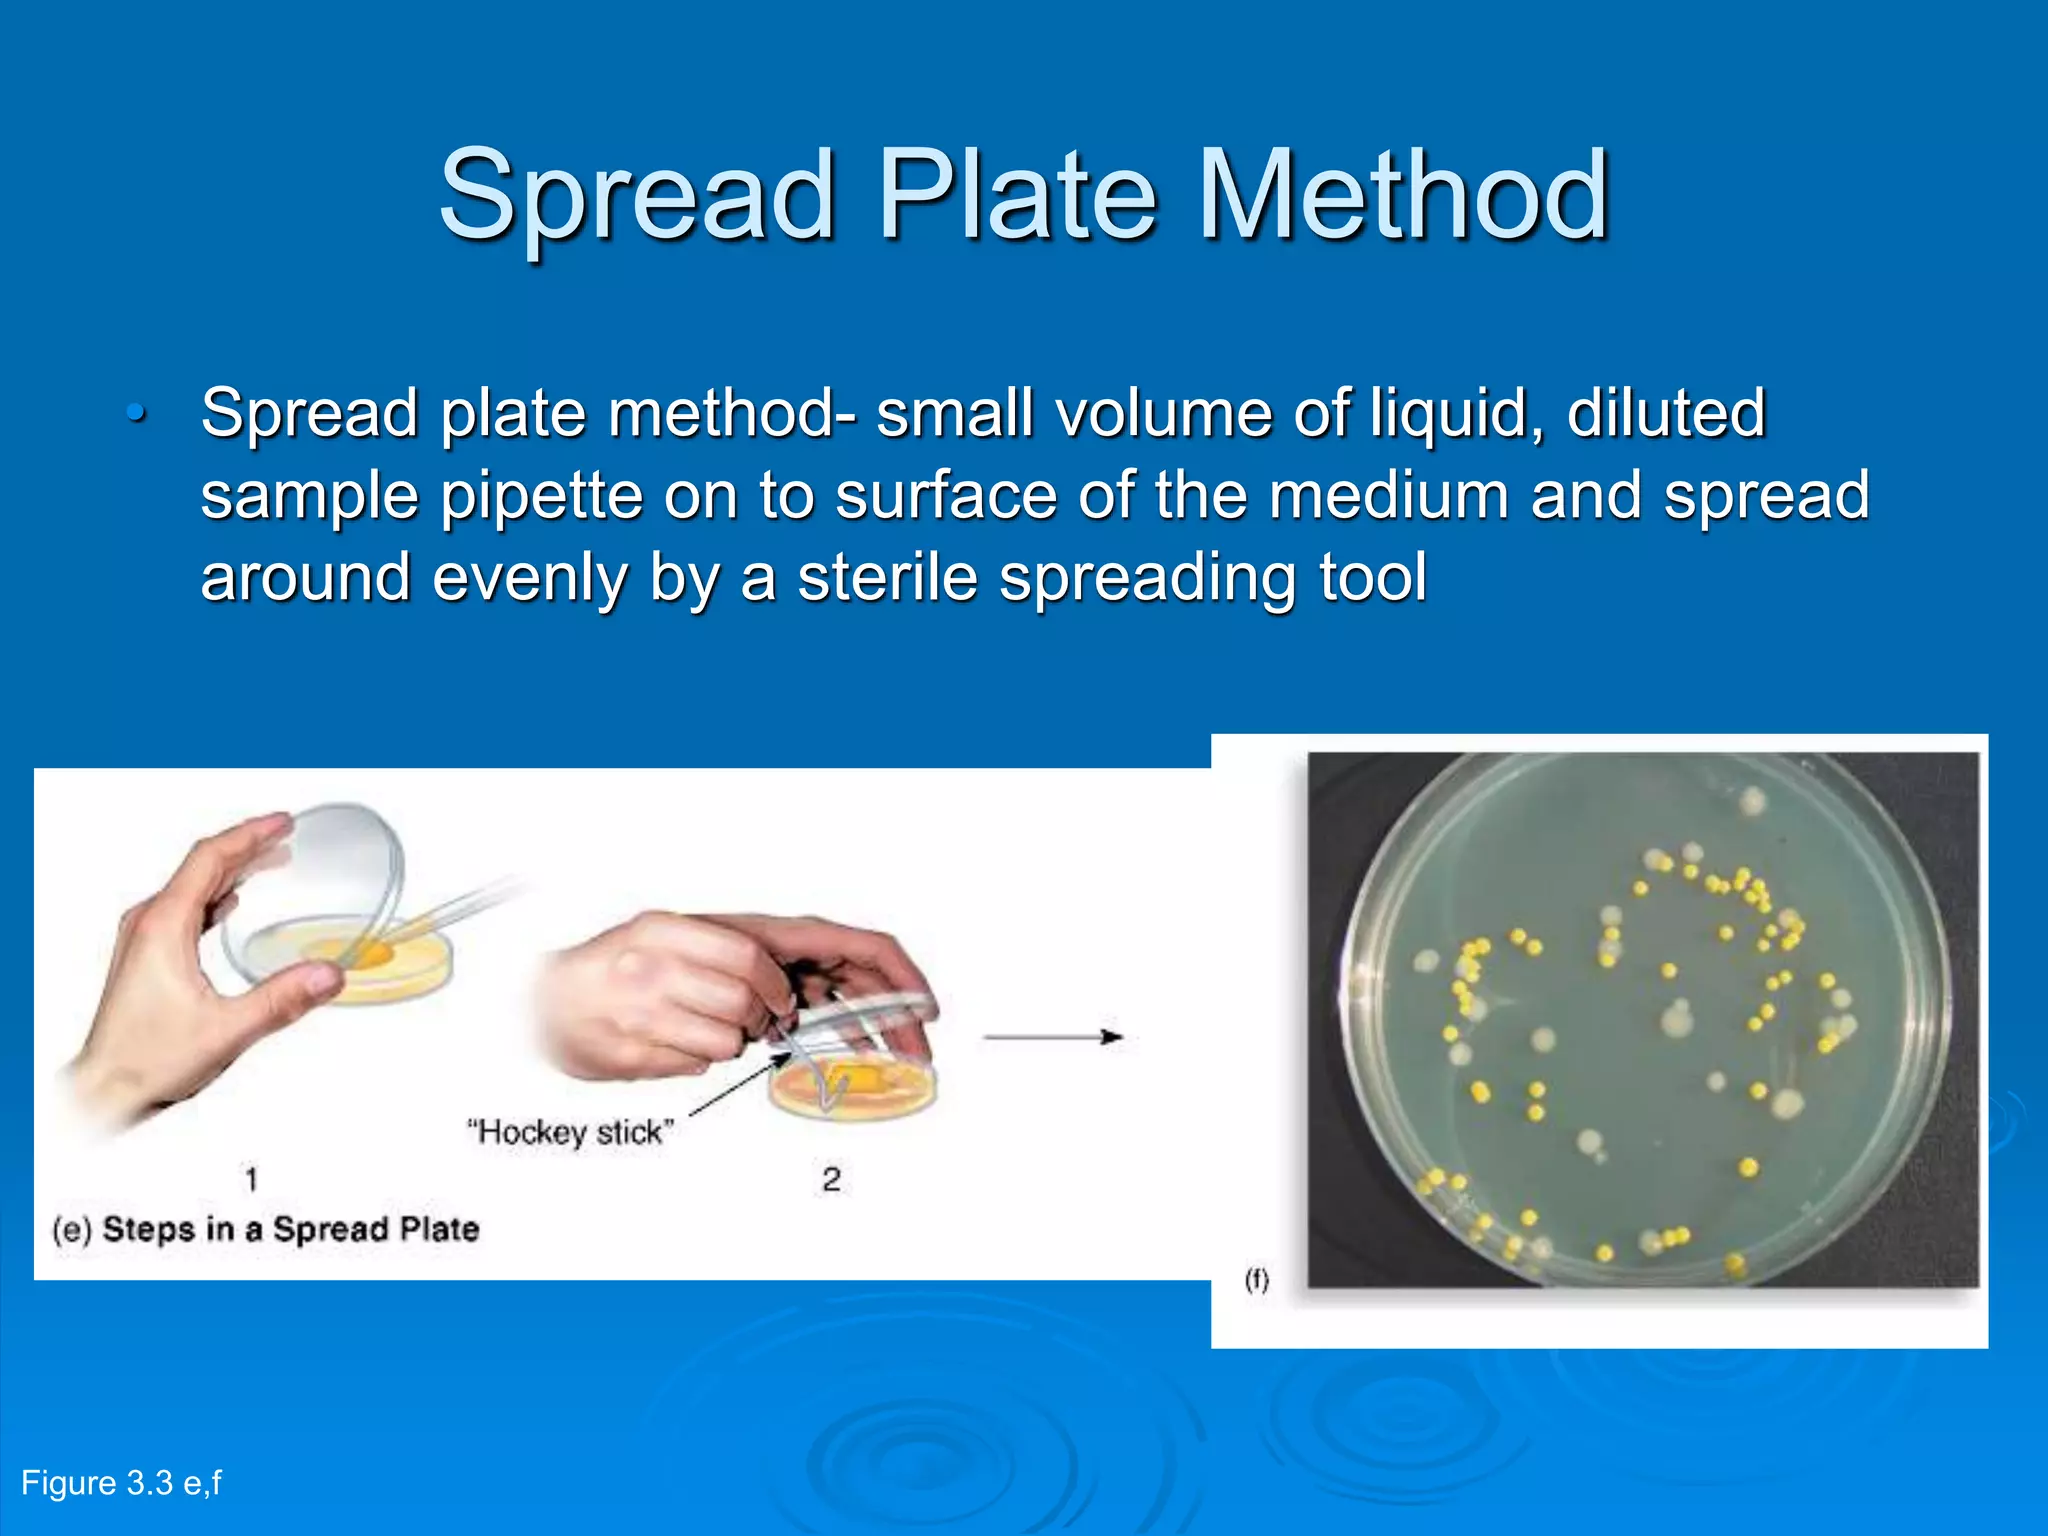
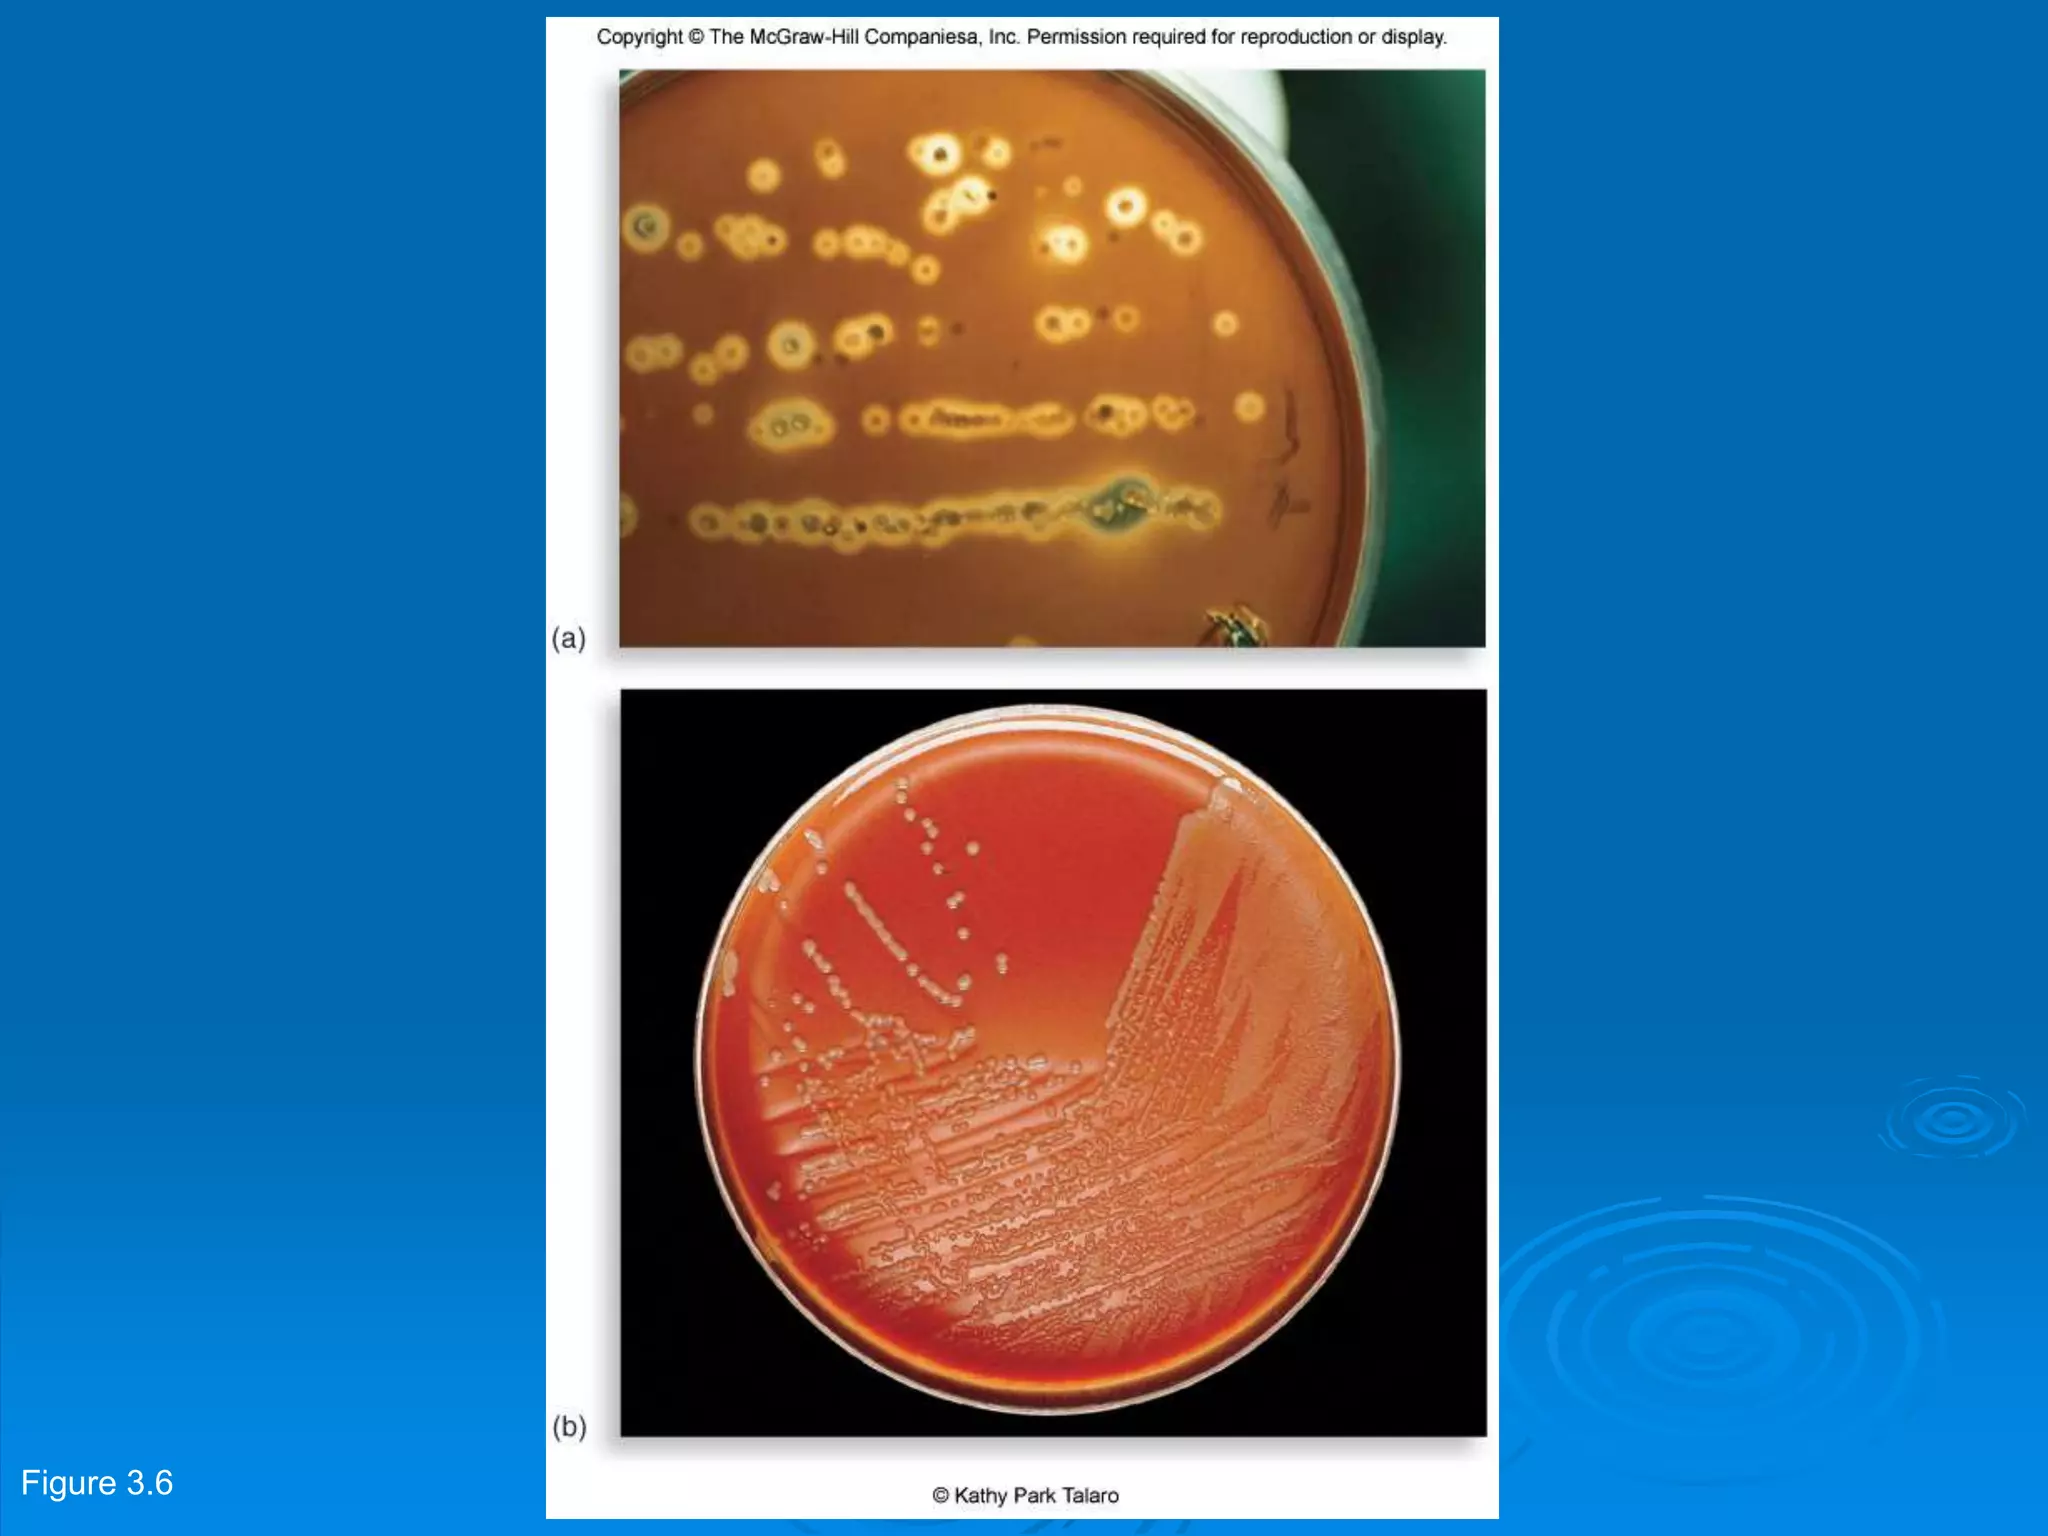
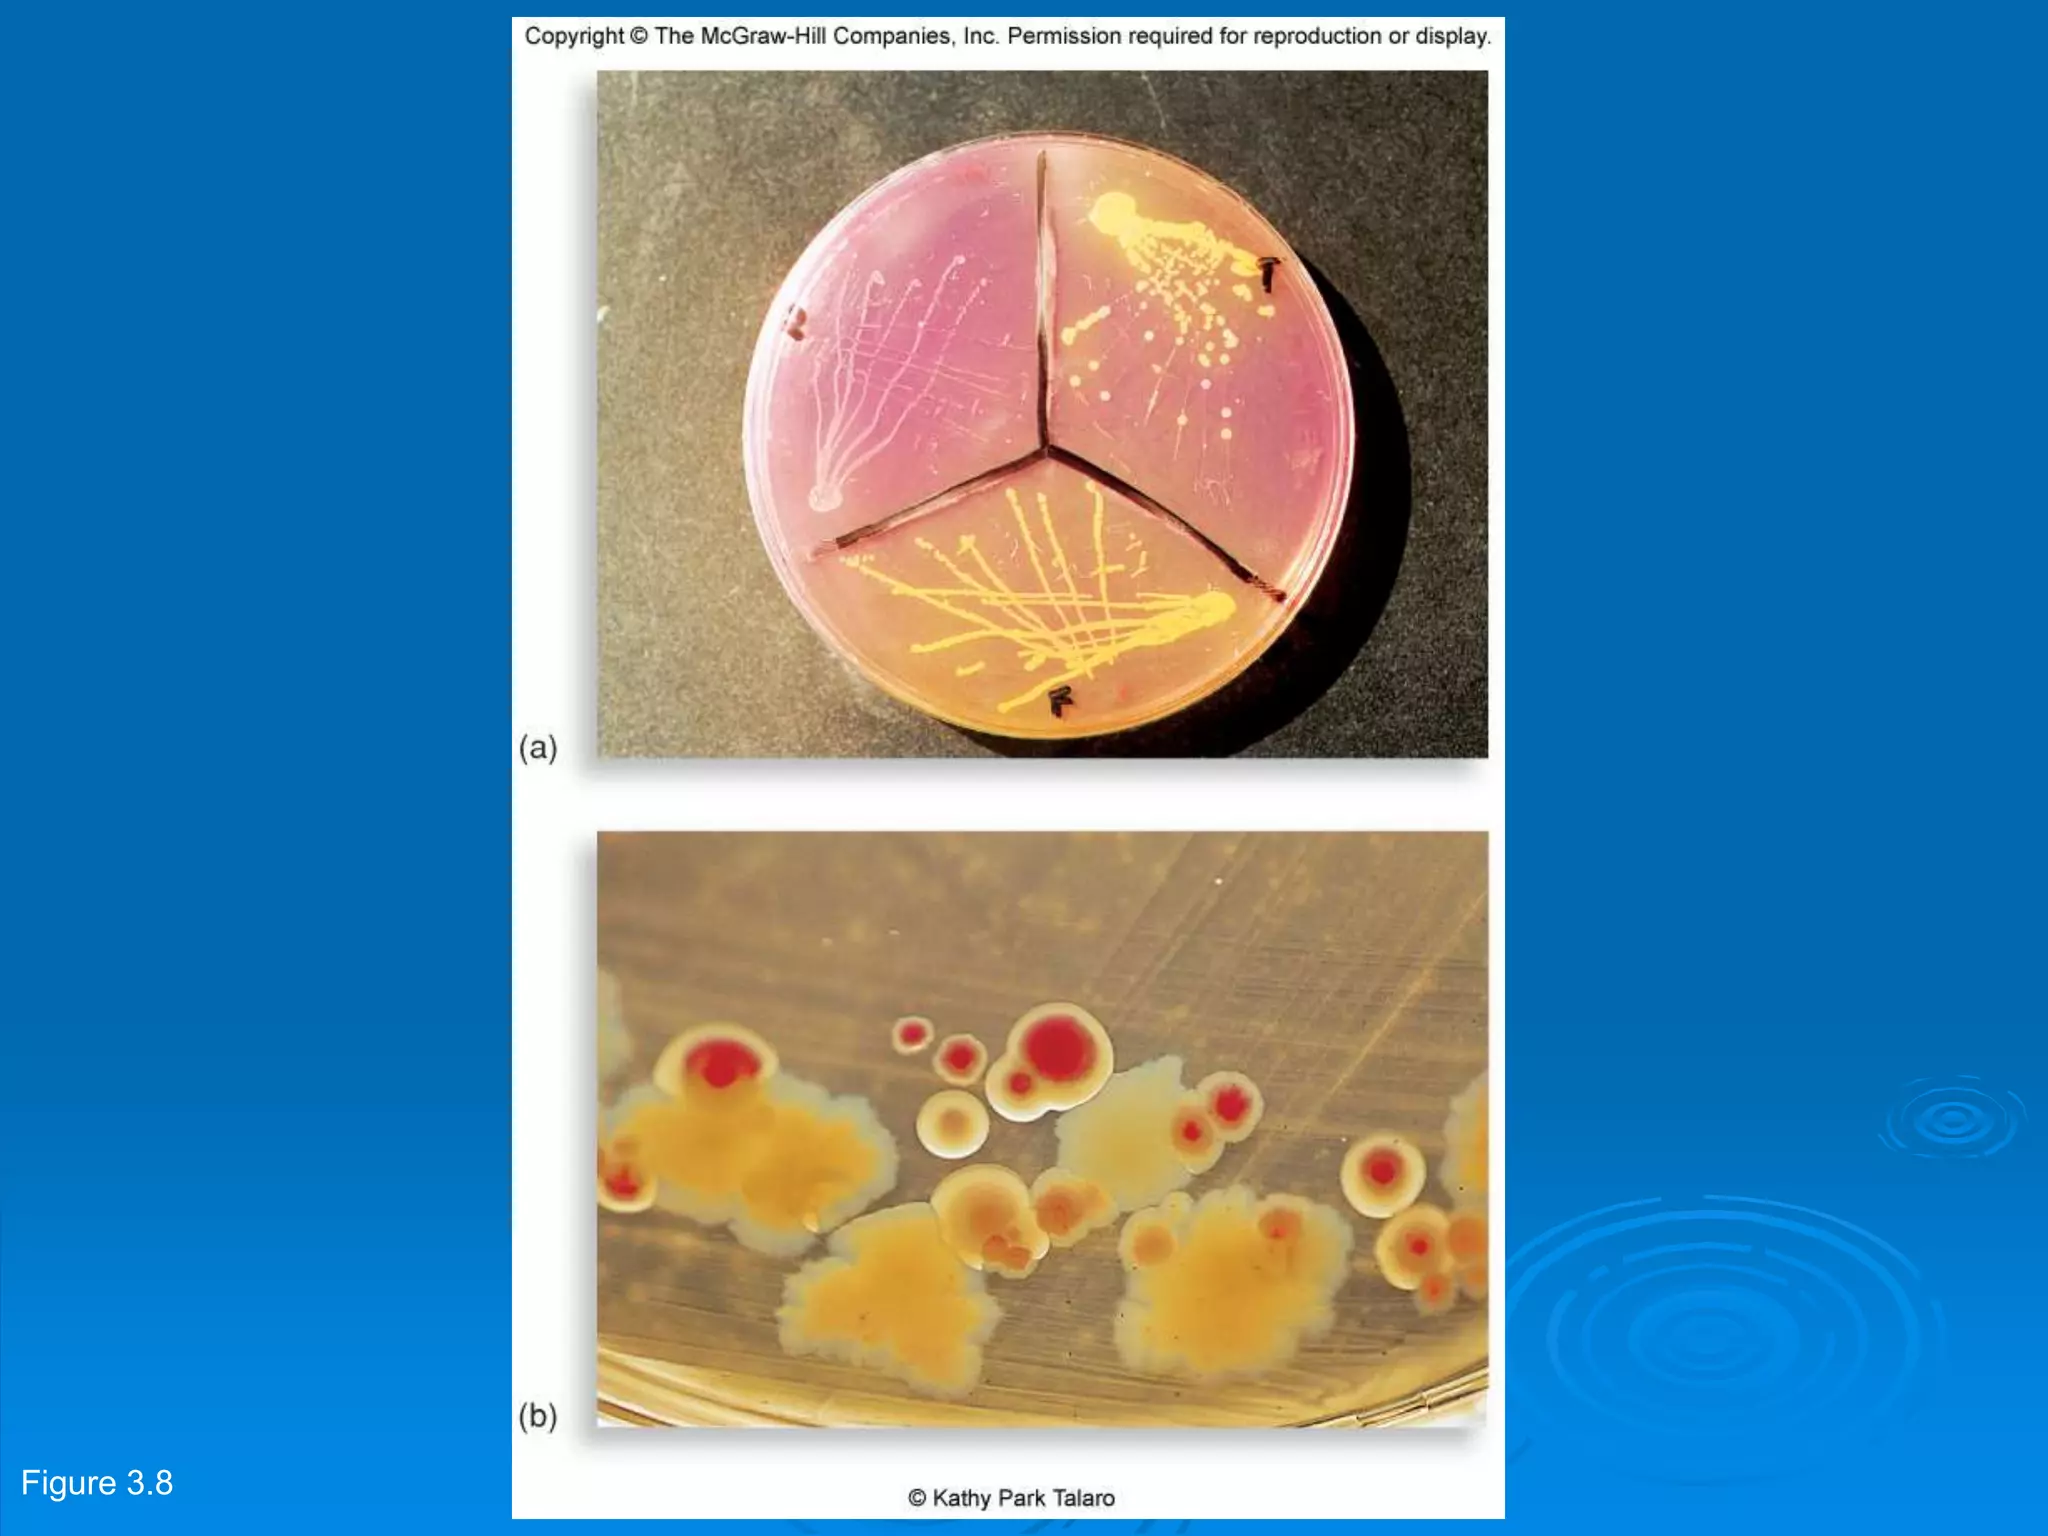

Microbiology techniques allow scientists to culture, examine, and identify microorganisms. There are five basic techniques: inoculation introduces a microbe sample into nutrient medium, incubation encourages growth, isolation separates individual species, inspection examines cultures visually, and identification determines the microbe. Microscopes are important tools, with brightfield, darkfield, phase contrast, fluorescence, confocal, transmission electron, and scanning electron variations. Staining techniques like Gram staining and acid-fast staining reveal cell structures and aid identification.